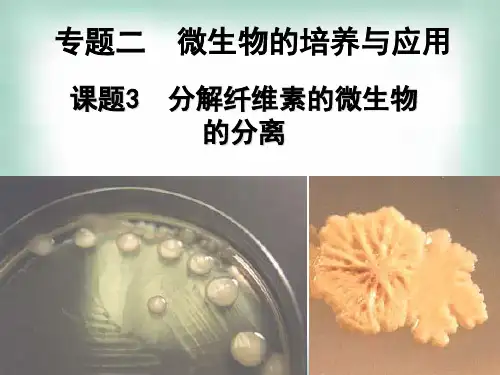

土壤中纤维素分解菌的分离ppt课件
- 格式:ppt
- 大小:512.50 KB
- 文档页数:19








土壤中纤维素分解菌的分离基本流程
一、准备土壤样品
1.采集土壤样品
2.确保样品来源地点多样化
3.确保样品新鲜度
二、筛选培养基
1.选择富含纤维素的培养基
2.考虑添加抑制其他微生物生长的物质
三、分离纤维素分解菌
1.制备稀释液
2.涂布法分离
(1)涂布土壤样品于培养基表面
(2)孵育培养皿
3.筛选产菌圈
(1)选择形态特征不同的产菌圈
(2)转接单菌落
四、纤维素分解菌的鉴定
1.形态学鉴定
(1)细胞形态
(2)芽胞形态
2.生理生化鉴定
(1)生长条件
(2)生化反应
五、保存纤维素分解菌
1.制备保存培养基
2.保存方式
(1)冷冻保存
(2)低温保存
六、应用研究
1.纤维素分解菌的代谢特性研究
2.纤维素降解酶的产出研究
以上是土壤中纤维素分解菌的分离基本流程。